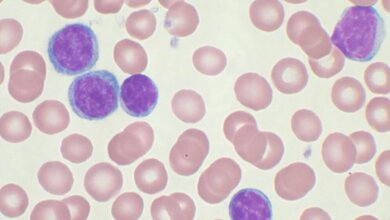
CLL

Das Immunsystem ist ein komplexes und präzise reguliertes System. Verschiedene aktivierende und hemmende Signale sorgen dafür, dass die Immunzellen Krankheitserreger abwehren, gleichzeitig aber nicht den eigenen Körper angreifen. Gerät dieses Gleichgewicht aus dem Lot, kann es zum Angriff auf körpereigene Zellen und Gewebe und zur Entstehung von Autoimmunerkrankungen wie Typ-1-Diabetes, Rheuma oder multipler Sklerose kommen.
IL-10-produzierende B-Lymphozyten
Die Steuerung aktivierender und hemmender Prozesse wird über Botenstoffe des Immunsystems (Zytokine) vermittelt. Eines der wichtigsten antientzündlichen Zytokine, das von regulatorischen Immunzellen freigesetzt wird, ist Interleukin-10 (IL-10). Es gibt zahlreiche Hinweise, dass auch IL-10-produzierende B-Lymphozyten, eine Gruppe weißer Blutkörperchen, regulatorische Effekte vermitteln, die das Fortschreiten von Autoimmunerkrankungen aufhalten oder das Abklingen entzündlicher Prozesse beschleunigen.
Ob es sich hierbei um eine Untergruppe der B-Lymphozyten handelt oder ob sich B-Lymphozyten unter bestimmten Voraussetzungen in regulatorische B-Zellen verwandeln, ist noch nicht geklärt. Die meisten bisherigen Untersuchungen hierzu beruhen auf tierexperimentellen Daten. Ein großes Hindernis auf dem Weg, regulatorische B-Zellen des Menschen zu untersuchen, ist das Fehlen spezifischer Oberflächenmarker, mit denen sich diese spezifische Gruppe von B-Zellen identifizieren lässt.
Über den Tumornekrosefaktor-Rezeptor 2 identifizierbar
Forscher um Prof. Isabelle Bekeredjian-Ding, Leiterin der Abteilung Mikrobiologie des Paul-Ehrlich-Instituts, haben gemeinsam mit Prof. Harald Wajant, Leiter der Abteilung für Molekulare Innere Medizin, Universitätsklinikum Würzburg, herausgefunden, dass IL-10-freisetzende B-Zellen über den Tumornekrosefaktor-Rezeptor 2 (TNFR2) identifiziert und sortiert werden können. „Unseren Forschungsergebnissen zufolge könnte TNFR2 als Marker für IL-10-sezernierende B-Zellen bei Infektionen und Autoimmunerkrankungen Verwendung finden. Noch zu klären ist die Rolle der TNFR2-bildenden B-Zellen bei der Entstehung und dem Fortschreiten immunvermittelter Erkrankungen und Infektionen. Hierzu sind Untersuchungen bei Patienten erforderlich“, sagt Prof. Isabelle Bekeredjian-Ding. (idw, red)
Ticha O, Moos L, Wajant H, Bekeredjian-Ding I (2018): Expression of Tumor Necrosis Factor Receptor 2 Characterizes TLR9-Driven Formation of Interleukin-10-Producing B Cells. Front Immunol 8: Article 1951, DOI: doi.org/10.3389/fimmu.2017.01951.
Artikel teilen